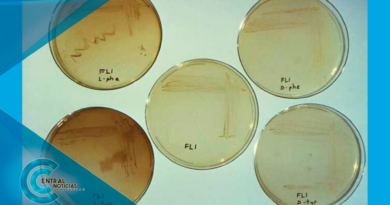

Luna llena de agosto: ¿cómo y cuándo ver la Luna de esturión en México?
La Luna llena de agosto será la octava colocación del satélite natural en su fase más brillante.

- ¿Cuándo? 19 de agosto de 2024
- ¿A qué hora? 12:25 horas del centro de México
- ¿Hora de mejor observación? 00:40 horas
Dado que la Luna llena alcanzará su máximo punto a las 12:25 horas, es probable que no pueda ser observada debido a la luz del Sol. Sin embargo, a partir de las 19:01, hora en que el astro rey se ha puesto, será posible disfrutar de este fenómeno astronómico.
El mejor momento para su observación será aproximadamente a las 00:40 horas, justo cuando la noche es más oscura.
De acuerdo con el Instituto Nacional de Astrofísica, Óptica y Electrónica (INAOE) la Luna llena de agosto se encontrará a una distancia geocéntrica de 361 mil 120 km y tendrá un tamaño angular de la Luna: 33,0 minutos de arco.
La Luna llena de agosto recibe su nombre de la tradición amerindia. Éste hace referencia a la abundante pesca, particularmente de esturión, que hay durante esta temporada del año. Y es que, el pescado era esencial para las tribus nativas americanas de la zona de los Grandes Lagos y el lago Champlain, indica el sitio Time and Date.
Por su parte, Farmer´s Almanac especifica que hay más de dos docenas de especies de esturión en el mundo, pero la “Luna del esturión” de agosto está relacionada específicamente con el esturión de lago ( Acipenser fulvescens ).
Según la publicación, anteriormente el esturión de lago era abundante y fácil de capturar en la frontera entre Nueva York y Vermont. Actualmente, los esturiones de lago son más raros que en siglos pasados, pero la asociación “Esturión Luna” permanece.
A pesar de que en occidente la Luna llena de agosto es conocida como Luna de esturión, lo cierto es que en otras culturas suele tener otros nombres, como:
- “Green Corn Moon”
- “Corn Moon”
- “Luna de las Cerezas Negras”
- “Luna de Ciruela”
- “Luna que desprende plumas”
- “Luna de los gansos”
- “Luna de los patos”
- “Luna seca”
- “Luna relámpago”
- “Luna de sombras de montaña”
- “Snow Moon”
- “Luna del Hambre”
Los celtas también la llamaron Luna de Disputa y Luna de Lince. Mientras que los anglosajones la nombraron como Luna de Grano.